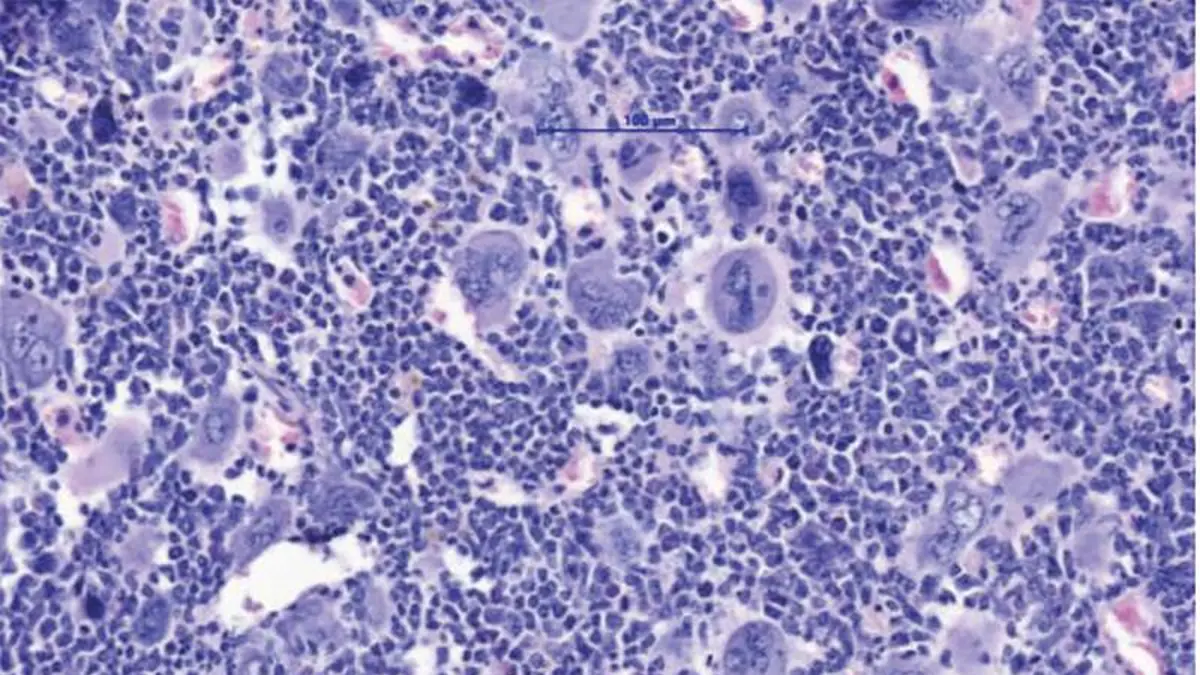
Histologische Gewebeaufnahme unter dem Mikroskop bei 100-facher Vergrößerung

Die neusten Beiträge

Gesteigerte Infektionsneigung nach Immuntherapie beim Multiplen Myelom

Fruquintinib bietet Tumorkontrolle und mehr gute Lebenszeit

Brustkrebsdiagnostik: Hohe Standards in der Pathologie
NLRP3-Hemmung mildert Knochenmarksfibrose und Thrombozytose bei MPN

KI revolutioniert molekulare Diagnose von Hirntumoren

Hodgkin-Lymphom: Entzündungs- und Stressmarker als Prädiktoren für CRCI

Überwachung der ZNS-Beteiligung bei AML durch ultrasensitive NGS

Sexuelle Gesundheit nach HCT: Barrieren bei AYA-Gesprächen

